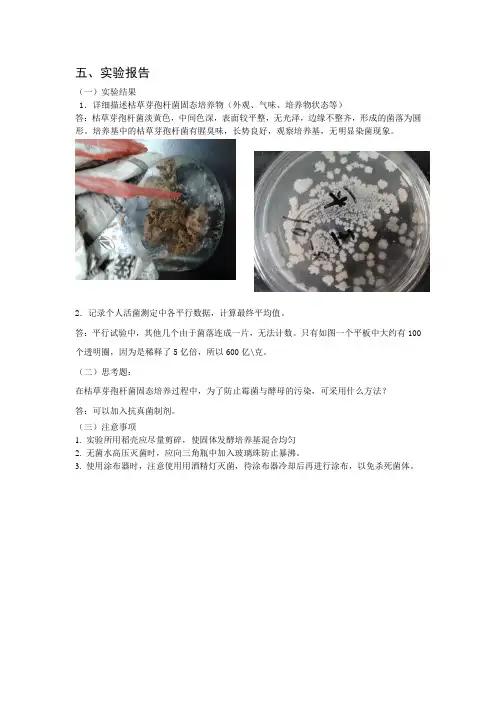

枯草芽孢杆菌实验报告
- 格式:doc
- 大小:109.50 KB
- 文档页数:11
(一)实验结果1.详细描述枯草芽孢杆菌固态培养物(外观、气味、培养物状态等)答:枯草芽孢杆菌淡黄色,中间色深,表面较平整,无光泽,边缘不整齐,形成的菌落为圆形。
培养基中的枯草芽孢杆菌有腥臭味,长势良好,观察培养基,无明显染菌现象。
2.记录个人活菌测定中各平行数据,计算最终平均值。
答:平行试验中,其他几个由于菌落连成一片,无法计数。
只有如图一个平板中大约有100个透明圈,因为是稀释了5亿倍,所以600亿\克。
(二)思考题:在枯草芽孢杆菌固态培养过程中,为了防止霉菌与酵母的污染,可采用什么方法?答:可以加入抗真菌制剂。
(三)注意事项1. 实验所用稻壳应尽量剪碎,使固体发酵培养基混合均匀2. 无菌水高压灭菌时,应向三角瓶中加入玻璃珠防止暴沸。
3. 使用涂布器时,注意使用用酒精灯灭菌,待涂布器冷却后再进行涂布,以免杀死菌体。
(一)实验结果1、详细记录实验过程中各参数及数据。
结果记录如表:糖化后,加入可乐瓶中的上清:400ml, 活化的酵母种液:10ml ,置于28℃的培养箱中静置培养36h左右。
2、对实验结果的判断与分析。
实验结果检验:○1二氧化碳生成的检验培养约48h后,观察瓶中混合液,淀粉大部分沉降在瓶底,上清浓度较稀,靠瓶壁边缘有一连串微小气泡○2酒精生成的检验打开瓶塞,闻到有浓重酒精气味。
取发酵液5ml, 加10%硫酸2ml,加1%K2Cr2O7溶液10-20滴,颜色由黄色变为黄绿色,稍加热后现象产生更快,更明显。
图示:酒精生成的检验结果左侧:蒸馏水5ml,颜色偏黄,透明度高右侧:发酵液5ml,黄绿色,与对照管有明显差异1、思考题:现有3株不同来源的酒精酵母,请设计实验判断哪株酵母发酵酒精能力最强?五、实验报告(一)实验结果1. 仔细观察固体培养基发酵前后的状态,并描述固体培养基发酵前:培养基颜色较浅,各成分(麸皮、稻草)新鲜,粘度大成团状固体培养基发酵后:培养基中产生较多黑色孢子及菌体,培养基营养成分被利用,体积缩小。

一、实验目的1. 掌握芽孢的基本特性及芽孢杀菌的原理。
2. 了解不同杀菌剂对芽孢的杀灭效果。
3. 培养实验操作技能,提高分析问题、解决问题的能力。
二、实验原理芽孢是细菌在不良环境下形成的一种特殊形态,具有很强的抵抗性。
芽孢的细胞壁厚、渗透压低,对高温、紫外线、化学药品等具有较强的抵抗力。
芽孢杀菌实验旨在通过观察不同杀菌剂对芽孢的杀灭效果,了解芽孢的抵抗力及杀菌原理。
三、实验材料1. 菌株:枯草芽孢杆菌2. 芽孢悬液:将枯草芽孢杆菌在肉汤培养基中培养,收集菌体,用无菌生理盐水洗涤,制成芽孢悬液。
3. 杀菌剂:70%乙醇、1%氯化钠溶液、1%氢氧化钠溶液、1%盐酸溶液、1%碘酊4. 实验器材:无菌试管、无菌吸管、酒精灯、显微镜、培养皿、恒温培养箱等四、实验方法1. 制备芽孢悬液:将枯草芽孢杆菌在肉汤培养基中培养,收集菌体,用无菌生理盐水洗涤,制成芽孢悬液,调整芽孢浓度为1×10^7 CFU/mL。
2. 分组处理:将芽孢悬液分别加入无菌试管中,每组10mL。
设置以下实验组:A组:70%乙醇处理组B组:1%氯化钠溶液处理组C组:1%氢氧化钠溶液处理组D组:1%盐酸溶液处理组E组:1%碘酊处理组F组:对照组(无菌生理盐水处理)3. 处理:将各实验组置于37℃恒温培养箱中处理30分钟。
4. 细菌计数:将处理后的芽孢悬液进行10倍稀释,取适量涂布于琼脂平板上,37℃恒温培养24小时,计算芽孢存活率。
5. 观察结果:通过显微镜观察芽孢的形态变化,分析不同杀菌剂对芽孢的杀灭效果。
五、实验结果与分析1. 芽孢存活率:各组芽孢存活率结果如下:A组:70%乙醇处理组,芽孢存活率=(对照组芽孢存活率-实验组芽孢存活率)/对照组芽孢存活率×100%≈0.0%B组:1%氯化钠溶液处理组,芽孢存活率≈15%C组:1%氢氧化钠溶液处理组,芽孢存活率≈10%D组:1%盐酸溶液处理组,芽孢存活率≈5%E组:1%碘酊处理组,芽孢存活率≈2%F组:对照组,芽孢存活率=100%2. 结果分析:(1)70%乙醇对芽孢具有较好的杀灭效果,芽孢存活率极低。

一、实验目的本研究旨在探究芽孢杆菌的抑菌性能,通过体外实验方法,评估其对特定细菌和真菌的抑菌效果,为芽孢杆菌在生物防治、食品保鲜等领域的应用提供科学依据。
二、实验材料1. 实验菌株:枯草芽孢杆菌(Bacillus subtilis)、金黄色葡萄球菌(Staphylococcus aureus)、大肠杆菌(Escherichia coli)、白色念珠菌(Candida albicans)。
2. 培养基:牛肉膏蛋白胨培养基、沙堡培养基。
3. 实验仪器:恒温培养箱、电子天平、移液器、牛津杯、无菌水、无菌滤纸等。
三、实验方法1. 菌悬液的制备:将实验菌株分别接种于牛肉膏蛋白胨培养基和沙堡培养基中,37℃恒温培养24小时,然后用无菌水稀释至适宜浓度。
2. 抑菌实验:- 将牛肉膏蛋白胨培养基和沙堡培养基分别铺成平板。
- 在平板中央放置牛津杯,并加入适量实验菌株菌悬液。
- 将平板置于恒温培养箱中,37℃培养24小时。
- 观察并记录抑菌圈的大小。
四、实验结果1. 枯草芽孢杆菌对细菌的抑菌效果:- 对金黄色葡萄球菌和大肠杆菌的抑菌效果较好,抑菌圈直径分别为15mm和12mm。
- 对枯草芽孢杆菌自身菌株无抑菌作用。
2. 枯草芽孢杆菌对真菌的抑菌效果:- 对白色念珠菌的抑菌效果较好,抑菌圈直径为10mm。
- 对枯草芽孢杆菌自身菌株无抑菌作用。
五、讨论与分析1. 抑菌效果分析:- 本实验结果表明,枯草芽孢杆菌对金黄色葡萄球菌、大肠杆菌和白色念珠菌具有一定的抑菌效果,说明其具有一定的生物防治潜力。
- 抑菌效果与菌株的种类和浓度有关,本实验中枯草芽孢杆菌的抑菌效果较好,可能与菌株本身的抑菌物质和代谢产物有关。
2. 实验局限性:- 本实验仅针对部分细菌和真菌进行了抑菌实验,未涉及更多菌株,实验结果可能存在局限性。
- 实验条件可能影响抑菌效果,如温度、pH值等。
六、结论本实验结果表明,枯草芽孢杆菌对金黄色葡萄球菌、大肠杆菌和白色念珠菌具有一定的抑菌效果,为芽孢杆菌在生物防治、食品保鲜等领域的应用提供了理论依据。


微生物技术综合实验年级:13级生物工程(专升本)班级:2013011201学号:1301014026姓名:徐红贞指导老师:刘凤霞教授日期:二零一三十月五号目录1实验目的及原理 (1)1.1实验目的 (1)1.2实验原理 (1)2实验材料 (1)2.1实验仪器 (1)2.2实验试剂 (1)2.3培养基 (2)2.3.1 生长培养基 (2)2.3.2鉴定培养基 (2)2.3.3摇瓶培养基 (2)3试验方法 (2)3.1仪器的准备 (2)3.2培养基的配置 (2)3.3初步筛选及鉴定 (2)3.3.1采集土样 (3)3.3.2富集培养 (3)3.3.3稀释分离、纯化 (3)3.3.4初筛 (3)3.4复筛及鉴定 (4)3.4.1革兰染色 (4)3.5酶活力的测定 (4)3.5.1摇瓶培养 (4)3.5.2酶液稀释 (4)3.5.3酶液测定 (4)4结果分析 (5)4.1平板涂布分离 (5)4.2平板划线分离 (5)4.3初筛 (5)4.4复筛 (5)4.5摇瓶培养 (6)4.6酶活力测定 (6)5参考资料 (7)6附录 (8)微生物上游技术综合实验枯草芽孢杆菌的分离、纯化、筛选及鉴定1.实验目的及原理1.1实验目的(1)学习从土壤中分离、纯化枯草芽孢杆菌的原理和方法。
(2)学习掌握枯草芽孢杆菌的鉴定方法。
(3)掌握微生物的摇瓶培养方法及淀粉酶活力的测定的原理和方法。
(4)培养学生综合应用微生物实验方法的能力。
(5)培养学生自行设计实验流程、综合分析问题解决问题和判断实验结果的能力。
1.2实验原理选择合适与待分离微生物的生长条件,如营养成分、酸碱度、温度和氧等要求,或加入某种抑制剂造成只利于该微生物生长,而抑制其他微生物的环境,从而淘汰一些不需要的微生物。
将土壤稀释液倒在不同类型的培养基平板上,在适宜的环境中培养几天,细菌或是其他的微生物便能在平板上生长繁殖,形成菌落。
将初次筛选得到的微生物接到淀粉培养基上培养,因为只有能够产生淀粉酶的细菌才能够利用培养基中的淀粉成分来完成自身的生命活动,才能够生存。

一、实验目的1. 通过紫外线诱变技术,提高微生物的产酶能力。
2. 筛选出具有较高酶活性的突变菌株。
二、实验原理紫外线诱变是一种物理诱变方法,通过紫外线照射微生物细胞,导致DNA分子发生突变,从而产生具有新的遗传特性的菌株。
本实验采用紫外线照射枯草芽孢杆菌,通过透明圈法初筛,筛选出具有较高淀粉酶活性的突变菌株。
三、实验材料1. 菌种:枯草芽孢杆菌2. 器材:紫外线灯、培养皿、涂布器、吸管、恒温摇床、培养箱、直尺、棉签、橡皮手套、洗耳球3. 培养基:可溶性淀粉培养基、牛肉膏培养基、0.5%碘液四、实验方法1. 紫外线照射:将枯草芽孢杆菌接种于牛肉膏培养基中,培养至对数生长期。
将培养好的菌液用无菌水稀释至一定浓度,取适量菌液均匀涂布于培养皿上,放入紫外灯照射箱中,照射距离为20-30cm,照射时间为1-3分钟。
照射过程中,严格控制死亡率在50%-80%。
2. 初筛:将照射后的菌落用无菌水洗涤,制成菌悬液。
取适量菌悬液涂布于可溶性淀粉培养基上,37℃培养24小时。
观察透明圈的大小,筛选出具有较大透明圈的突变菌株。
3. 酶活性测定:采用淀粉酶活力测定方法,测定筛选出的突变菌株的淀粉酶活性,并与原始菌株进行对比。
五、实验结果1. 紫外线照射后,部分菌株出现透明圈,且透明圈大小不一。
2. 经过初筛,筛选出10株具有较大透明圈的突变菌株。
3. 酶活性测定结果显示,筛选出的10株突变菌株的淀粉酶活性均高于原始菌株,其中菌株A的淀粉酶活性最高,达到原始菌株的1.8倍。
六、讨论与分析1. 紫外线照射能够有效诱导枯草芽孢杆菌产生淀粉酶活性突变菌株,且突变频率较高。
2. 初筛过程中,透明圈大小与淀粉酶活性具有一定的相关性,透明圈越大,酶活性越高。
3. 实验结果表明,通过紫外线诱变技术,可以有效地提高枯草芽孢杆菌的产酶能力,为微生物育种提供了一种新的方法。
七、结论1. 紫外线诱变技术是一种有效提高微生物产酶能力的方法。
2. 本实验筛选出的突变菌株具有较高淀粉酶活性,为后续的发酵生产和应用提供了有利条件。

微生物技术综合实验年级:13级生物工程(专升本)班级:2013011201学号:***********名:***指导老师:刘凤霞教授日期:二零一三十月五号目录1实验目的及原理 (1)1.1实验目的 (1)1.2实验原理 (1)2实验材料 (1)2.1实验仪器 (1)2.2实验试剂 (1)2.3培养基 (2)2.3.1 生长培养基 (2)2.3.2鉴定培养基 (2)2.3.3摇瓶培养基 (2)3试验方法 (2)3.1仪器的准备 (2)3.2培养基的配置 (2)3.3初步筛选及鉴定 (2)3.3.1采集土样 (3)3.3.2富集培养 (3)3.3.3稀释分离、纯化 (3)3.3.4初筛 (3)3.4复筛及鉴定 (4)3.4.1革兰染色 (4)3.5酶活力的测定 (4)3.5.1摇瓶培养 (4)3.5.2酶液稀释 (4)3.5.3酶液测定 (4)4结果分析 (5)4.1平板涂布分离 (5)4.2平板划线分离 (5)4.3初筛 (5)4.4复筛 (5)4.5摇瓶培养 (6)4.6酶活力测定 (6)5参考资料 (7)6附录 (8)微生物上游技术综合实验枯草芽孢杆菌的分离、纯化、筛选及鉴定1.实验目的及原理1.1实验目的(1)学习从土壤中分离、纯化枯草芽孢杆菌的原理和方法。
(2)学习掌握枯草芽孢杆菌的鉴定方法。
(3)掌握微生物的摇瓶培养方法及淀粉酶活力的测定的原理和方法。
(4)培养学生综合应用微生物实验方法的能力。
(5)培养学生自行设计实验流程、综合分析问题解决问题和判断实验结果的能力。
1.2实验原理选择合适与待分离微生物的生长条件,如营养成分、酸碱度、温度和氧等要求,或加入某种抑制剂造成只利于该微生物生长,而抑制其他微生物的环境,从而淘汰一些不需要的微生物。
将土壤稀释液倒在不同类型的培养基平板上,在适宜的环境中培养几天,细菌或是其他的微生物便能在平板上生长繁殖,形成菌落。
将初次筛选得到的微生物接到淀粉培养基上培养,因为只有能够产生淀粉酶的细菌才能够利用培养基中的淀粉成分来完成自身的生命活动,才能够生存。


实验题目枯草芽孢杆菌的分离、纯化和鉴定一、实验目的枯草芽孢杆菌(Bacillus subtilis)广泛存在于土壤、植物根际体表等,其好氧、嗜温,极易分离与培养。
由于枯草芽孢杆菌生长快,具有广谱抗菌活性和很强的抗逆能力,并且对人畜无毒,不污染环境,因此已作为一种理想的生防菌广泛应用于多种植物病害的防治且备受关注。
本实验通过温度筛选法和选择性培养基筛选法分离枯草芽孢杆菌,并针对其生理生化特征进行纯化和鉴定及16S rDNA基因序列进行分析。
二、实验原理枯草芽孢杆菌,是芽孢杆菌属的一种。
单个细胞 0.7~0.8×2~3微米,着色均匀。
无荚膜,周生鞭毛,能运动。
革兰氏阳性菌,芽孢0.6~0.9×1.0~1.5微米,椭圆倒柱状,位于菌体中央或稍偏,芽孢形成后菌体不膨大。
菌落表面粗糙不透明,污白色或微黄色,在液体培养基中生长时,常形成皱醭。
需氧菌。
可利用蛋白质、多种糖及淀粉,分解色氨酸形成吲哚。
在遗传学研究中应用广泛,对此菌的嘌呤核苷酸的合成途径与其调节机制研究较清楚。
广泛分布在土壤及腐败的有机物中,易在枯草浸汁中繁殖。
枯草芽孢杆菌的分离方法:(1)温度筛选法:枯草芽孢杆菌能产生芽孢,在孢子状态下稳定性好,能耐氧化;耐挤压;耐高温,能长期耐60°C高温,在120°C温度下能存活20分钟,利用枯草芽孢杆菌的这一特性,可利用高温水浴使不能产生芽孢的细菌失去活性,得到芽孢菌属,经过进一步的分离及生理生化鉴定得到枯草芽孢杆菌。
(2)选择性培养基筛选法:枯草芽孢杆菌培养基的组分是由葡萄糖、蛋白胨、酵母膏、磷酸二氢钾、碳酸钙等5种原料构成,将5种原料作为枯草芽孢杆菌培养有影响的因素,通过试验数理统计的直观和理论分析,对其配方进行优化,当培养基的配方为无水葡萄糖3.50g/L、蛋白胨0.83g/L、酵母膏0.50g/L、磷酸二氢钾0.35g/L和碳酸钙0.25g/L,温度(34±2)℃时,培养16h即可达到生长峰值。

五、实验报告
(一)实验结果
1.详细描述枯草芽孢杆菌固态培养物(外观、气味、培养物状态等)
答:枯草芽孢杆菌淡黄色,中间色深,表面较平整,无光泽,边缘不整齐,形成的菌落为圆形。
培养基中的枯草芽孢杆菌有腥臭味,长势良好,观察培养基,无明显染菌现象。
2.记录个人活菌测定中各平行数据,计算最终平均值。
答:前两个平板中菌落过于密集,导致无法计数。
第三个平板中大约有100个菌落,因为是稀释了5×107倍,所以5亿/克。
(二)思考题:
在枯草芽孢杆菌固态培养过程中,为了防止霉菌与酵母的污染,可采用什么方法?
答:可以加入抗真菌制剂。
(三)注意事项
1. 实验所用稻壳应尽量剪碎,使固体发酵培养基混合均匀
2. 无菌水高压灭菌时,应向三角瓶中加入玻璃珠,以防止暴沸。
3. 使用涂布器时,注意使用用酒精灯灭菌,待涂布器冷却后再进行涂布,以免杀死菌体。

枯草芽孢杆菌的分离、提纯摘要枯草芽孢杆菌,是芽孢杆菌属的一种。
单个细胞0.7~0.8×2~3微米,着色均匀。
无荚膜,周生鞭毛,能运动。
革兰氏阳性菌,芽孢0.6~0.9×1.0~1.5微米,椭圆到柱状,位于菌体中央或稍偏,芽孢形成后菌体不膨大。
菌落表面粗糙不透明,污白色或微黄色,在液体培养基中生长时,常形成皱醭。
需氧菌。
可利用蛋白质、多种糖及淀粉,分解色氨酸形成吲哚。
在遗传学研究中应用广泛,对此菌的嘌呤核苷酸的合成途径与其调节机制研究较清楚。
广泛分布在土壤及腐败的有机物中,易在枯草浸汁中繁殖。
关键词枯草芽孢杆菌提纯无菌培养一、实验目的1、学习从土壤中分离、纯化枯草芽孢杆菌的原理和方法。
2、学习和掌握枯草芽孢杆菌的鉴定方法。
3、锻炼培养学生综合应用微生物实验方法的能力。
4、培养学生自行设计实验流程、综合分析问题解决问题和判断实验结果的能力。
二、实验原理芽孢是芽孢杆菌属和梭菌属细菌生长到一定阶段形成的一种抗逆性很强的休眠体结构,也被称为内生孢子,通常为圆形或椭圆形。
枯草培养法是利用枯草杆菌产生芽孢这一性质。
因为芽孢对不良环境有较强的抗性。
所以枯草在煮沸过程中,不含芽孢的细菌被杀死,而含有芽孢的枯草杆菌能够生存下来,在适宜的条件下进行繁殖生长。
芽孢染色法是利用同一种细菌的芽孢和菌体对不同染料的亲和力不同的原理,用不同的染料进行着色,因芽孢壁厚,透性低,着色脱色均较困难,而使芽孢和菌体呈不同的颜色便于区分。
因此芽孢染色采用弱碱性染料孔雀绿,在加热的条件下进行,因孔雀绿与菌体结合较差,所以易被水冲洗掉,而芽孢中的孔雀绿却难溶出,水洗后,再用一种呈红色的碱性染料加以复染,结果,菌体为红色,芽孢为绿色。
三、实验器材1、培养基淀粉培养基2、材料:枯草3、器材:显微镜、三角烧瓶、温箱、酒精灯、棉塞、接种环、无菌玻璃涂棒、无菌吸管、无菌培养皿、涂布器等。
4、流程:倒平板→制备枯草稀释液→涂布→培养→初筛→复筛四、实验步骤1、土样的采集:取土壤表层5-10cm下的肥土100g左右,把采取的土壤放入纸袋带回实验室。
枯草芽孢杆菌实验报告枯草芽孢杆菌是一种常见的土壤细菌,具有很高的生物活性,对有机物质的分解和土壤健康有重要的作用。
本次实验旨在研究枯草芽孢杆菌的生长和代谢特性,通过定量测定菌落数量和产生抗生素的能力来评估其生物活性和潜在应用价值。
实验步骤:1.枯草芽孢杆菌的培养:取一瓶含有枯草芽孢杆菌的培养基,用无菌环针在琼脂培养基上划线,然后在37°C恒温培养箱中培养24小时。
2. 菌落计数:取一定量的培养基溶液,制备一系列稀释液。
然后,取1ml稀释液分别均匀涂布于琼脂培养基板上。
将琼脂培养基板置于37°C恒温培养箱中培养24小时。
3.菌落计数:取出培养好的琼脂培养基板,利用计数板或显微镜计数室计数菌落的数量。
将每个培养基板上菌落数量相近的三个培养基板进行组合平均,得到最终的菌落数量。
4.抗生素生产测定:取一定量的培养基,加入适当的抗生素敏感菌株。
利用纸片扩散法将培养基涂布于含有抗生素敏感菌株的琼脂培养基板上。
5.抗生素生产测定:将琼脂培养基板置于37°C恒温培养箱中培养24小时。
观察抗生素的形成情况,记录菌落周围的抑制圈直径。
实验结果:1. 菌落计数:测定了不同稀释液下的菌落数量。
结果表明,枯草芽孢杆菌在培养基中的生长有一定的限度。
菌落数量在1:10^-6的稀释液中最多,大约为10^6 cfu/ml。
2. 抗生素生产测定:枯草芽孢杆菌在琼脂培养基中显示出抗生素的生产能力。
抑制圈的直径与抗生素的浓度和种类有关。
枯草芽孢杆菌产生的抑制圈直径在15mm到25mm之间。
实验讨论:1.菌落计数的结果表明,枯草芽孢杆菌在一定程度上受到培养基成分和营养状况的影响,适宜的培养基组分可以促进菌落的生长和繁殖。
2.抗生素生产测定结果表明,枯草芽孢杆菌具有抗生素的生产潜力。
抗生素的生产能力可能与其竞争环境中的营养选择有关。
3.枯草芽孢杆菌的抗生素生产能力对于农业和医学领域具有重要意义。
进一步研究其抗生素成分和抗生素的生产调控机制,可以为抗生素的发现和利用提供新思路。
微生物技术综合实验年级:13级生物工程(专升本)班级:2013011201学号:***********名:***指导老师:刘凤霞教授日期:二零一三十月五号目录1实验目的及原理 (1)1.1实验目的 (1)1.2实验原理 (1)2实验材料 (1)2.1实验仪器 (1)2.2实验试剂 (1)2.3培养基 (2)2.3.1 生长培养基 (2)2.3.2鉴定培养基 (2)2.3.3摇瓶培养基 (2)3试验方法 (2)3.1仪器的准备 (2)3.2培养基的配置 (2)3.3初步筛选及鉴定 (2)3.3.1采集土样 (3)3.3.2富集培养 (3)3.3.3稀释分离、纯化 (3)3.3.4初筛 (3)3.4复筛及鉴定 (4)3.4.1革兰染色 (4)3.5酶活力的测定 (4)3.5.1摇瓶培养 (4)3.5.2酶液稀释 (4)3.5.3酶液测定 (4)4结果分析 (5)4.1平板涂布分离 (5)4.2平板划线分离 (5)4.3初筛 (5)4.4复筛 (5)4.5摇瓶培养 (6)4.6酶活力测定 (6)5参考资料 (7)6附录 (8)微生物上游技术综合实验枯草芽孢杆菌的分离、纯化、筛选及鉴定1.实验目的及原理1.1实验目的(1)学习从土壤中分离、纯化枯草芽孢杆菌的原理和方法。
(2)学习掌握枯草芽孢杆菌的鉴定方法。
(3)掌握微生物的摇瓶培养方法及淀粉酶活力的测定的原理和方法。
(4)培养学生综合应用微生物实验方法的能力。
(5)培养学生自行设计实验流程、综合分析问题解决问题和判断实验结果的能力。
1.2实验原理选择合适与待分离微生物的生长条件,如营养成分、酸碱度、温度和氧等要求,或加入某种抑制剂造成只利于该微生物生长,而抑制其他微生物的环境,从而淘汰一些不需要的微生物。
将土壤稀释液倒在不同类型的培养基平板上,在适宜的环境中培养几天,细菌或是其他的微生物便能在平板上生长繁殖,形成菌落。
将初次筛选得到的微生物接到淀粉培养基上培养,因为只有能够产生淀粉酶的细菌才能够利用培养基中的淀粉成分来完成自身的生命活动,才能够生存。
枯草芽孢杆菌实验报告枯草芽孢杆菌实验报告引言:枯草芽孢杆菌(Bacillus subtilis)是一种常见的细菌,广泛存在于土壤和水体中。
它以其多样化的生理特性和广泛的应用领域而受到科学家们的广泛关注。
本实验旨在研究枯草芽孢杆菌的生长特性、产孢能力以及对环境的适应能力。
材料与方法:1. 枯草芽孢杆菌培养基的制备:将蛋白胨、氯化钠和葡萄糖溶解于蒸馏水中,加热至溶解,然后用菌液过滤器过滤,得到无菌的培养基。
2. 枯草芽孢杆菌的培养:将枯草芽孢杆菌接种于培养基中,放入恒温培养箱中,在适宜的温度和湿度下培养。
3. 枯草芽孢杆菌的生长曲线测定:每隔一定时间,取一定量的菌液进行测定,记录其光密度值,绘制生长曲线图。
4. 枯草芽孢杆菌的产孢能力测定:将培养基中的菌液经离心分离,取上清液,利用显微镜观察孢子的形态和数量。
结果与讨论:1. 枯草芽孢杆菌的生长特性:通过测定菌液的光密度值,我们可以观察到枯草芽孢杆菌的生长曲线。
在实验中,菌液的光密度值随时间的增加而增加,呈现出指数增长的趋势。
这说明枯草芽孢杆菌具有较快的生长速度和较高的繁殖能力。
此外,我们还观察到在培养基中,枯草芽孢杆菌呈现出白色或灰色的菌落,这与其常见的形态特征相符。
2. 枯草芽孢杆菌的产孢能力:通过观察上清液中的孢子形态和数量,我们可以评估枯草芽孢杆菌的产孢能力。
实验结果显示,枯草芽孢杆菌能够产生大量的椭圆形或椭圆球形的孢子,并且孢子的数量随着培养时间的延长而增加。
这表明枯草芽孢杆菌具有较强的产孢能力,这对于其在环境中的存活和传播具有重要意义。
3. 枯草芽孢杆菌的环境适应能力:枯草芽孢杆菌是一种广泛存在于土壤和水体中的细菌,具有较强的环境适应能力。
在实验中,我们将枯草芽孢杆菌培养于不同的温度和pH值条件下,并观察其生长情况。
结果显示,枯草芽孢杆菌在较宽范围的温度和pH值条件下均能够生长,但在极端的环境条件下,如过高或过低的温度、极酸性或极碱性的pH值,其生长速度和繁殖能力会受到一定的限制。
五、实验报告
(一)实验结果
1.详细描述枯草芽孢杆菌固态培养物(外观、气味、培养物状态等)答:枯草芽孢杆菌淡黄色,中间色深,表面较平整,无光泽,边缘不整齐,形成的菌落为圆形。
培养基中的枯草芽孢杆菌有腥臭味,长势良好,观察培养基,无明显染菌现象。
2.记录个人活菌测定中各平行数据,计算最终平均值。
答:前两个平板中菌落过于密集,导致无法计数。
第三个平板中大约有100个菌落,因为是稀释了5×107倍,所以5亿/克。
(二)思考题:
在枯草芽孢杆菌固态培养过程中,为了防止霉菌与酵母的污染,可采用什么方法?
答:可以加入抗真菌制剂。
(三)注意事项
1. 实验所用稻壳应尽量剪碎,使固体发酵培养基混合均匀
2. 无菌水高压灭菌时,应向三角瓶中加入玻璃珠,以防止暴沸。
3. 使用涂布器时,注意使用用酒精灯灭菌,待涂布器冷却后再进行涂布,以免杀死菌体。
1. 掌握芽孢染色的原理和方法。
2. 观察和区分芽孢与菌体的形态结构。
3. 理解芽孢在细菌生存过程中的重要性。
二、实验原理芽孢是细菌在恶劣环境下形成的一种特殊休眠体,具有厚而致密的壁,通透性低,对高温、冷冻、射线、干燥、化学药品和染料等具有很强的抵抗力。
因此,在常规染色方法中,芽孢不易着色或仅显淡色。
芽孢染色法利用芽孢与菌体对染料的亲和力不同,采用特殊染色方法,使芽孢和菌体呈现不同的颜色,便于区分。
三、实验材料1. 菌种:枯草芽孢杆菌2. 染料:孔雀绿染液、番红染液、复染液(如石炭酸复红液和吕氏美蓝液)3. 仪器:显微镜、载波片、接种环、酒精灯、滴管等四、实验步骤1. 将枯草芽孢杆菌接种于营养琼脂平板,培养24小时。
2. 将培养好的菌落挑取少许,制作成涂片。
3. 将涂片用火焰固定。
4. 将涂片滴加孔雀绿染液,染色5-10分钟。
5. 水洗涂片,去除多余的染料。
6. 将涂片滴加番红染液,复染1-2分钟。
7. 水洗涂片,去除多余的染料。
8. 将涂片滴加复染液,染色1-2分钟。
9. 水洗涂片,去除多余的染料。
10. 将涂片晾干,用显微镜观察。
在显微镜下观察,菌体呈红色,芽孢呈绿色。
芽孢直径大于菌体,位于菌体中央,极端或次极端,使菌体膨大呈梭状。
六、实验分析1. 芽孢染色法是一种特殊的染色方法,可以有效地观察和区分芽孢与菌体的形态结构。
2. 芽孢是细菌在恶劣环境下形成的一种特殊休眠体,具有厚而致密的壁,对各种不利因素具有很强的抵抗力。
3. 芽孢在细菌的生存过程中具有重要意义,可以保护细菌度过恶劣环境。
七、实验讨论1. 在实验过程中,染色时间和染液浓度对实验结果有一定影响,需要根据实际情况进行调整。
2. 芽孢染色法可以应用于多种细菌的芽孢观察,如枯草芽孢杆菌、梭菌等。
3. 芽孢染色法是一种基础实验技术,对于微生物学学习和研究具有重要意义。
八、实验总结通过本次实验,我们掌握了芽孢染色的原理和方法,观察了芽孢与菌体的形态结构,了解了芽孢在细菌生存过程中的重要性。
枯草芽孢杆菌乳糖发酵实验结果在咱们今天的实验室里,有个超级有趣的实验,那就是关于枯草芽孢杆菌和乳糖的发酵。
大家可能会问:“这是什么玩意儿?”别着急,我慢慢给你们唠叨。
枯草芽孢杆菌是一种神奇的小生物,它们在土壤里可活得好好的,还能帮我们分解一些东西。
听说,它们还特别喜欢乳糖,这可是牛奶里的糖分哦。
想象一下,咱们把这种细菌放进乳糖的环境里,会发生什么有趣的事呢?实验开始的时候,咱们先准备好一大瓶乳糖溶液。
然后把这些小家伙放进去,就像给他们开了个“自助餐”,哇,眼看着它们一个个兴奋得欢腾起来。
你知道吗?这些细菌就像是聚会的孩子,看到美味的食物就像打了鸡血,疯狂地开始啃啃啃。
然后,我们就静静地观察它们的变化。
谁知道它们竟然会把乳糖转化为其他的东西,听起来有点魔法的感觉吧。
过了一段时间,我们开始看到了变化。
液体的颜色变了,原本清澈的溶液变得浑浊起来。
就像是泡澡的水,放进去了泡泡,越泡越热闹。
这时候,实验室里充满了一种特殊的气味,有点酸酸的,像是没喝完的牛奶。
但是啊,这不是坏事,这正是细菌们忙着发酵的证据呢!它们就像厨师,把乳糖做成了酸乳,搞得整个实验室都是浓浓的奶香味,真让人忍不住想尝一口。
咱们还得检测一下这发酵的效果。
于是,我们拿出了试纸,准备看看这些小家伙到底做了多少“好事”。
当试纸放进去的瞬间,哇塞,颜色变了,简直就像变魔术一样!实验结果显示,枯草芽孢杆菌果然没有食言,它们把乳糖变成了乳酸,真是太厉害了。
没想到,简单的实验能带来如此大的惊喜。
这个实验不仅仅是科学的体现,还是一种乐趣。
想象一下,细菌们就像小朋友在玩捉迷藏,一个个钻来钻去,做着不同的事情。
我们观察着它们的变化,心里就充满了期待,仿佛在看一场精彩的表演。
实验结束后,大家都笑得合不拢嘴,简直是收获了满满的快乐。
这样的实验,真是让人欲罢不能。
我们还讨论了一下这些细菌在生活中的应用。
比如说,枯草芽孢杆菌其实可以帮助提高土壤的肥力,还能在发酵食品中大显身手。
微生物技术综合实验年级:13级生物工程(专升本)班级:2013011201学号:***********名:***指导老师:刘凤霞教授日期:二零一三十月五号目录1实验目的及原理 (1)1.1实验目的 (1)1.2实验原理 (1)2实验材料 (1)2.1实验仪器 (1)2.2实验试剂 (1)2.3培养基 (2)2.3.1 生长培养基 (2)2.3.2鉴定培养基 (2)2.3.3摇瓶培养基 (2)3试验方法 (2)3.1仪器的准备 (2)3.2培养基的配置 (2)3.3初步筛选及鉴定 (2)3.3.1采集土样 (3)3.3.2富集培养 (3)3.3.3稀释分离、纯化 (3)3.3.4初筛 (3)3.4复筛及鉴定 (4)3.4.1革兰染色 (4)3.5酶活力的测定 (4)3.5.1摇瓶培养 (4)3.5.2酶液稀释 (4)3.5.3酶液测定 (4)4结果分析 (5)4.1平板涂布分离 (5)4.2平板划线分离 (5)4.3初筛 (5)4.4复筛 (5)4.5摇瓶培养 (6)4.6酶活力测定 (6)5参考资料 (7)6附录 (8)微生物上游技术综合实验枯草芽孢杆菌的分离、纯化、筛选及鉴定1.实验目的及原理1.1实验目的(1)学习从土壤中分离、纯化枯草芽孢杆菌的原理和方法。
(2)学习掌握枯草芽孢杆菌的鉴定方法。
(3)掌握微生物的摇瓶培养方法及淀粉酶活力的测定的原理和方法。
(4)培养学生综合应用微生物实验方法的能力。
(5)培养学生自行设计实验流程、综合分析问题解决问题和判断实验结果的能力。
1.2实验原理选择合适与待分离微生物的生长条件,如营养成分、酸碱度、温度和氧等要求,或加入某种抑制剂造成只利于该微生物生长,而抑制其他微生物的环境,从而淘汰一些不需要的微生物。
将土壤稀释液倒在不同类型的培养基平板上,在适宜的环境中培养几天,细菌或是其他的微生物便能在平板上生长繁殖,形成菌落。
将初次筛选得到的微生物接到淀粉培养基上培养,因为只有能够产生淀粉酶的细菌才能够利用培养基中的淀粉成分来完成自身的生命活动,才能够生存。
故在淀粉部分不显现蓝色,出现透明圈,可以通过透明圈的大小来初步判断培养物中是否有产淀粉酶微生物及产淀粉酶的能力。
2. 实验材料2.1实验仪器无菌玻璃涂棒无菌移液管接种环无菌培养皿土样电子天平三角瓶烧杯试管酒精灯擦镜纸载玻片吸水纸恒温摇床恒温培养箱高压蒸汽灭菌锅玻璃珠显微镜无菌铲胶头滴管记号笔试管架棉塞牛皮纸报纸细绳无菌纸袋电炉搪瓷缸分光光度计恒温水浴锅白瓷皿等。
2.2 实验试剂○1碘液储备液:称取22.0g碘化钾溶于约300mL水中,加入11.0g碘,搅拌溶液,移入500mL容量瓶,用水定容,贮于棕色瓶中备用(每月配制一次)。
○2碘液使用液:称取20.0g碘化钾,溶于约300mL水中,移入500mL容量瓶中,枯草芽孢杆菌的分离、纯化、筛选及鉴定准确加入2.00mL碘液储备液,用水定容,贮于棕色瓶中备用(每天配制一次)。
○320g/L可溶性淀粉溶液:称取2.00g可溶性淀粉于250mL烧杯中,用少量水调成糊状,在搅拌下加入约80mL沸水,继续加热煮沸至透明(20min),冷却后用水定容至100mL(此溶液需当天配制,存放冰箱备用)○4pH6.0磷酸缓冲溶液:称取磷酸氢二钠45.23g,柠檬酸8.07g,用水溶解定容至1000mL,配好后用酸度计校正其pH至6.0○50.1mol/L盐酸溶液:量取9.4mL浓盐酸,用水稀释定容至1000mL。
草酸铵结晶紫番红碘液95%酒精无菌水香柏油吸水纸擦镜纸2.3 培养基2.3.1 斜面培养基牛肉膏3g,蛋白胨10g,NaCl 5g琼脂15~20g,自来水1000ml,pH 7.2~7.42.3.2鉴定培养基可溶性淀粉20g, 硝酸钾1g,磷酸氢二钾0.5g, 氯化钠0.5g, 硫酸镁0.5g,硫酸亚铁0.01g,琼脂20 g, 自来水1000ml,校正pH至7.2~7.4,2.3.3摇瓶培养基玉米粉2g,黄豆饼粉1.5g,氯化钙0.02g,硫酸镁0.02g,氯化钠0.25g,磷酸氢二钾0.2g,磷酸氢二钠0.2g,柠檬酸钠0.2g,硫酸铵0.075g,(溶解后加),校正pH值7.0 3.实验方法3.1仪器的准备①准备试管若干支,洗净晾干,其中7支各装9毫升蒸馏水(或自来水),上塞,10支一捆121度高压灭菌20-30分钟。
②培养皿若干个并洗净晾干,每5个一包,高压灭菌。
③移液管洗净塞上脱脂棉,用报纸条包好、捆扎高压灭菌。
④准备一个三角瓶装入自来水300-400毫升,上棉塞并用纸包好高压灭菌。
3.2培养基的配置按各培养基配方配置培养基,并将生长培养基分装6支试管,上棉塞,放入大烧杯中待灭菌。
其余的培养基分装入三角瓶内,上棉塞,包扎灭菌。
3.3初步筛选及鉴定微生物上游技术综合实验3.3.1采集土样用无菌铲铲去表层5-10厘米,用无菌器具规范采取50-100克,装入无菌纸袋中并记录采集的时间、地点及植被情况等等。
3.3.2富集培养将采集的土样称取5克,放入装有45毫升无菌水的三角瓶中,放入恒温振荡培养箱中于37度下培养10-20分钟。
3.3.3稀释分离、纯化取装有9毫升无菌水试管5支,用记号笔编上10-2 、10-3、10-4、10-5、10-6、10-7取已稀释成10-1土壤液,振荡后静置30秒,用无菌的移液管吸取1毫升土壤悬液加入10-2的无菌水试管中,并在试管内轻轻反复吸数次,使之充分混匀,即成10-2土壤稀释液。
同法从10-2的试管中吸取1毫升稀释液加入编号为10-3的无菌水试管中,混匀后即为10-3土壤稀释液,依次连续稀释为10-4、10-5、10-6、10-7土壤稀释液。
并做9个平板,每个稀释度做3个。
用一支新的无菌移液管,由低浓度开始(10-3,10-4,10-5),从各试管土壤稀释液中各吸取1ml,对号注入生长培养基平板上,用灼烧冷却后的无菌玻璃棒涂匀,每个浓度做三个平板(重复),倒置于37℃温箱中培养24到48小时。
培养后,挑选10-5梯度上的单菌落进行平板划线分离,共划四个平板,并进行编号1、2、3号,于37℃倒置培养24h。
3.3.4初筛透明圈实验将疑枯草芽孢杆菌用平板划线法接种于鉴定培养基上,在37℃恒温培养箱中培养24-48h后,用胶头滴管将碘液直接滴于菌落周围,观察现象。
阳性反应(淀粉被分解)菌落周围出现透明圈,呈紫色;阴性反应则无透明环,呈深蓝色。
(透明圈的大小可初步判断该菌水解能力的强弱,即产生胞外淀粉酶活力的高低)。
3.4复筛及鉴定革兰氏染色:(1)涂片:左手持培养皿,右手持接种环,用接种环从培养皿中取一环菌,于载玻片中央涂成薄层(事先在背面做好标记圆圈)即可,或先滴一滴无菌水于载玻片中央,用接种环从斜面上挑出少许,与载玻片上的水滴混合均匀,涂成一薄层。
枯草芽孢杆菌的分离、纯化、筛选及鉴定(2)干燥:涂片后在室温下自然干燥,也可在酒精灯上略加温,使之迅速干燥,但勿靠近火焰。
(3)固定:常用高温进行固定。
即手持载玻片一端,标本面朝上,在灯的火焰外侧快速来回移动3~4次,共约3~4秒。
要求玻片温度不超过60℃,以玻片背面触及手背皮肤不觉过烫为宜,放置待冷后染色。
(4)染色○1初染:加草酸铵结晶紫一滴,约一分钟,水洗至流下的水无色为准。
○2媒染:滴加碘液冲去残水,并覆盖约一分钟,水洗至流下的水无色为准。
○3脱色:将载玻片上的水用吸水纸吸干,并衬以白背景,用95%酒精滴洗至流出酒精刚刚不出现紫色时为止,约20—30秒,立即用水冲净酒精,至流下的水为无色为准。
○4复染:吸水纸吸干,后用番红液染1—2分钟,水洗至流下的水为无色为准。
(5).镜检:干燥后,置显微镜下观察。
革兰氏阴性菌呈红色,革兰氏阳性菌呈紫色。
以分散开的细菌的革兰氏染色反应为准,过于密集的细菌,常常呈假阳性。
3.5酶活力的测定3.5.1摇瓶培养选产生透明圈最大的菌株进行摇瓶培养,将菌溶于5毫升无菌生理盐水中吸取此液体加入液体培养液中,30度摇瓶培养72小时。
3.5.2酶液稀释取发酵液进行4000r/min 离心5分钟,取上清夜,用磷酸缓冲液稀释酶活力为65—70U/ml,便于准确测定。
3.5.3酶液测定○1吸取20.00mL 20g/L可溶性淀粉溶液和5.00mLpH6.0磷酸缓冲溶液于大试管中,在60℃恒温水浴中预热平衡5min。
○2加入待测酶液1.00mL,立即摇匀并用秒表计时,准确反应5min。
○3立即用结晶干燥的吸管吸取上述反应液 1.00mL至预先盛有0.50mL 0.1mol/L HCl溶液和5.00mL碘液使用液的10mL具塞比色管中,摇匀。
○4以0.50mL 0.1mol/LHCl溶液5.00mL碘液使用液和1.00mL磷酸缓冲溶液的混合微生物上游技术综合实验溶液做空白,于660nm波长下,用1cm比色皿迅速测定其吸光度,根据吸光度查附录“吸光度与测试α-淀粉酶酶浓度对照表”,求得测试溶液的浓度C 。
4.结果分析4.1平板涂布分离经48h培养后,结果见表4-1表4-1 平板涂布菌落状况1 2 3 菌落形态10-3 10-4 10-5菌体成片生长,有3个单菌落平板四周有菌生长有杂菌生长充满平板菌体成片生长,有1个单菌落菌体充满整个平板,无单菌落有杂菌生长,并有单菌落菌落充满整个平板,有5个单菌落有2个单菌落有1个单菌落有褶皱,表面光滑,湿润呈圆形乳白色经分析,由于操作不熟练导致10-4、10-5梯度有少量菌体生长,10-6梯度中菌体少且培养时为倒置培养从而导致无菌落生长。
4.2平板划线分离挑选10-5梯度的菌落进行平板划线分离,经48h培养后,每平板最大菌落结果见表4-2表4-2 平板划线菌落状况1号2号3号4号大小/cm 形态0.5表面光滑,0.7有褶皱呈0.8乳白色或0.4淡黄色圆形经分析,由于菌体为野生菌而各自的生长能力不同,从而导致菌落大小不同。
4.3初筛培养24h后,结果见表4-3表4-3 透明圈大小1号2号3号4号透明圈大小/㎝ 1.9 2.2 2.6 2.0枯草芽孢杆菌的分离、纯化、筛选及鉴定经分析,菌落周伟产生透明圈,可判断该菌可以产生淀粉酶,由于菌体本身利用淀粉的能力不同,而导致透明圈直径各异。
4.4复筛在显微镜下观察,发现菌体成杆状且呈现蓝紫色,初步判断其为杆菌且为阳性菌。
4.5摇瓶培养培养52h后,用碘液检验,结果见表4-4表4-4 24h碘液检验1号2号3号4号颜色深蓝色深蓝色焦糖色棕色表4-5 72h碘液检验1号2号3号4号颜色深蓝色深蓝色棕黄色棕黄色经分析,3号、4号摇瓶中的菌产生淀粉酶的能力较强,故对其进行淀粉酶活力测定。
4.6酶活力测定在660nm波长下,吸光度见表4-6表4-6 吸光度1 2 3吸光度﹙A﹚0.110 0.120 0.100根据附录表可知,当吸光度为0.174时,相对应的酶浓度为4.329u/mL,当吸光度为0.214时,相对应的酶浓度为4.156u/mL,则其平均浓度为4.243 u/mL。